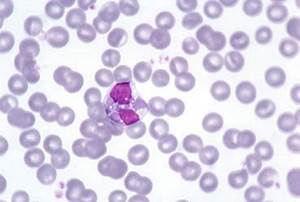
Эозинофилы у собаки Фото

Эозинофилы у собаки в общем клиническом анализе крови
Эозинофилы – это клетки крови, относящиеся к лейкоцитам. В своей цитоплазме эозинофилы содержат гранулы, которые при окраске мазка крови эозином приобретают
Эозинофилы производятся костным мозгом и недолго содержатся в периферической крови: они могут покидать кровеносные сосуды и мигрировать в ткани (преимущественно в легкие,
Эозинофилы могут поглощать и инактивировать такие вещества, как гепарин, гистамин, лейкотриены и т.д. Таким образом, эозинофилы регулируют аллергические реакции.
Содержащиеся в эозинофилах вещества токсичны для некоторых клеток организма, поэтому длительная инфильтрация тканей эозинофилами может провоцировать повреждение тканей и приводить к заболеваниям (эозинофильный гастрит, эозинофильный миозит, эозинофильный менингоэнцефаломиелит и т.д.).
Доказано, что в лабораторных условиях эозинофилы способны уничтожать паразитов.
В организме эозинофилы фагоцитируют («поедают») вредные агенты, проникшие в ткани, и «отмеченные» соответствующими антителами (комплексы
Причины повышения содержания эозинофилов
Причины повышения процентного содержания эозинофилов в анализе крови у собак:
- физиологические суточные колебания (ночью в периферической крови эозинофилов на треть больше, чем днем)
- аллергические реакции (особенно бронхиальная астма и кожные проявления)
- паразитозы (гельминты, простейшие)
- некоторые злокачественные новообразования
- гнойные и воспалительные заболевания
- интоксикации
- гипоадренокортицизм (болезнь Аддисона)
- гиперэозинофильный синдром.
Причин для эозинофилии множество, поэтому только на основании количества эозинофилов в мазке крови поставить диагноз не представляется возможным. Необходимо учитывать данные анамнеза, осмотра и дополнительных диагностических исследований.
Варшавское шоссе, 125 стр.1. тел. 8 (499) 372-27-37
Почитайте отзывы о нашем ветеринарном центре.
Позвоните по номеру 8 (495) 241 64 95 и запишитесь на консультацию прямо сейчас.
(с) Ветеринарный центр лечения и реабилитации животных «Зooстатус».
Варшавское шоссе, 125 стр.1.

